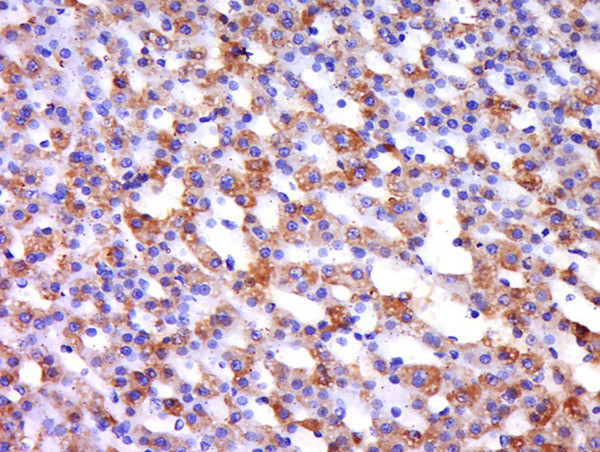
Integrin alpha L/CD11a Antibody in Immunohistochemistry (Paraffin) (IHC (P))

Search
Bioss
Integrin alpha L/CD11a Polyclonal Antibody
{{$productOrderCtrl.translations['antibody.pdp.commerceCard.promotion.promotions']}}
{{$productOrderCtrl.translations['antibody.pdp.commerceCard.promotion.viewpromo']}}
{{$productOrderCtrl.translations['antibody.pdp.commerceCard.promotion.promocode']}}: {{promo.promoCode}} {{promo.promoTitle}} {{promo.promoDescription}}. {{$productOrderCtrl.translations['antibody.pdp.commerceCard.promotion.learnmore']}}
图: 1 / 2
Integrin alpha L/CD11a Antibody (BS-1804R) in IHC (P)


产品信息
BS-1804R
种属反应
宿主/亚型
分类
类型
抗原
偶联物
形式
浓度
规格
纯化类型
保存液
内含物
保存条件
运输条件
靶标信息
CD11a (LFA-1 alpha, ITGAL) together with CD18 constitute leukocyte function-associated antigen 1 (LFA-1), the alphaLbeta2 integrin. CD11a is implicated in activation of LFA-1 complex. CD11a plays a central role in leukocyte intercellular adhesion through interactions with its ligands, ICAMs 1-3 (intercellular adhesion molecules 1 through 3), and also functions in lymphocyte costimulatory signaling. CD11a is expressed on the plasma membrane of leukocytes in a low-affinity conformation. Cell stimulation by chemokines or other signals leads to induction the high-affinity conformation, which supports tight binding of CD11a to its ligands, the intercellular adhesion molecules ICAM-1, -2, -3. CD11a is thus involved in interaction of various immune cells and in their tissue-specific settlement, but participates also in control of cell differentiation and proliferation and of T-cell effector functions. Blocking of CD11a function by specific antibodies or small molecules has become an important therapeutic approach in treatment of multiple inflammatory diseases. For example, humanized anti- CD11a antibody Efalizumab (Raptiva) is being used to interfere with T cell migration to sites of inflammation, binding of cholesterol-lowering drug simvastatin to CD11a allosteric site leads to immunomodulation and increase in lymphocytic cholinergic activity. Two transcript variants encoding different isoforms of CD11a have been found. Diseases associated with CD11a dysfunction include benign cephalic histiocytosis and leukocyte adhesion deficiency.
仅用于科研。不用于诊断过程。未经明确授权不得转售。
篇参考文献 (0)
生物信息学
蛋白别名: alpha L integrin; antigen CD11A (p180), lymphocyte function-associated antigen 1, alpha polypeptide; antigen CD11A p180; CD11 antigen-like family member A; CD11a; integrin alpha L; Integrin alpha-L; integrin alphaL; integrin gene promoter; integrin, alpha L (antigen CD11A (p180), lymphocyte function-associated antigen 1; alpha polypeptide); Leukocyte adhesion glycoprotein LFA-1 alpha chain; Leukocyte function-associated molecule 1 alpha chain; LFA-1 alpha; LFA-1A; Ly-15; Lymphocyte antigen 15; lymphocyte function associated antigen 1, alpha polypeptide; lymphocyte function-associated antigen 1, alpha polypeptide; lymphocyte function-associated antigen-1; unnamed protein product
基因别名: (p180); CD11A; ITGAL; LFA-1; LFA-1A; LFA1A; Ly-15; Ly-21
UniProt ID: (Human) P20701, (Mouse) P24063
Entrez Gene ID: (Rabbit) 100356927, (Human) 3683, (Rat) 308995, (Mouse) 16408